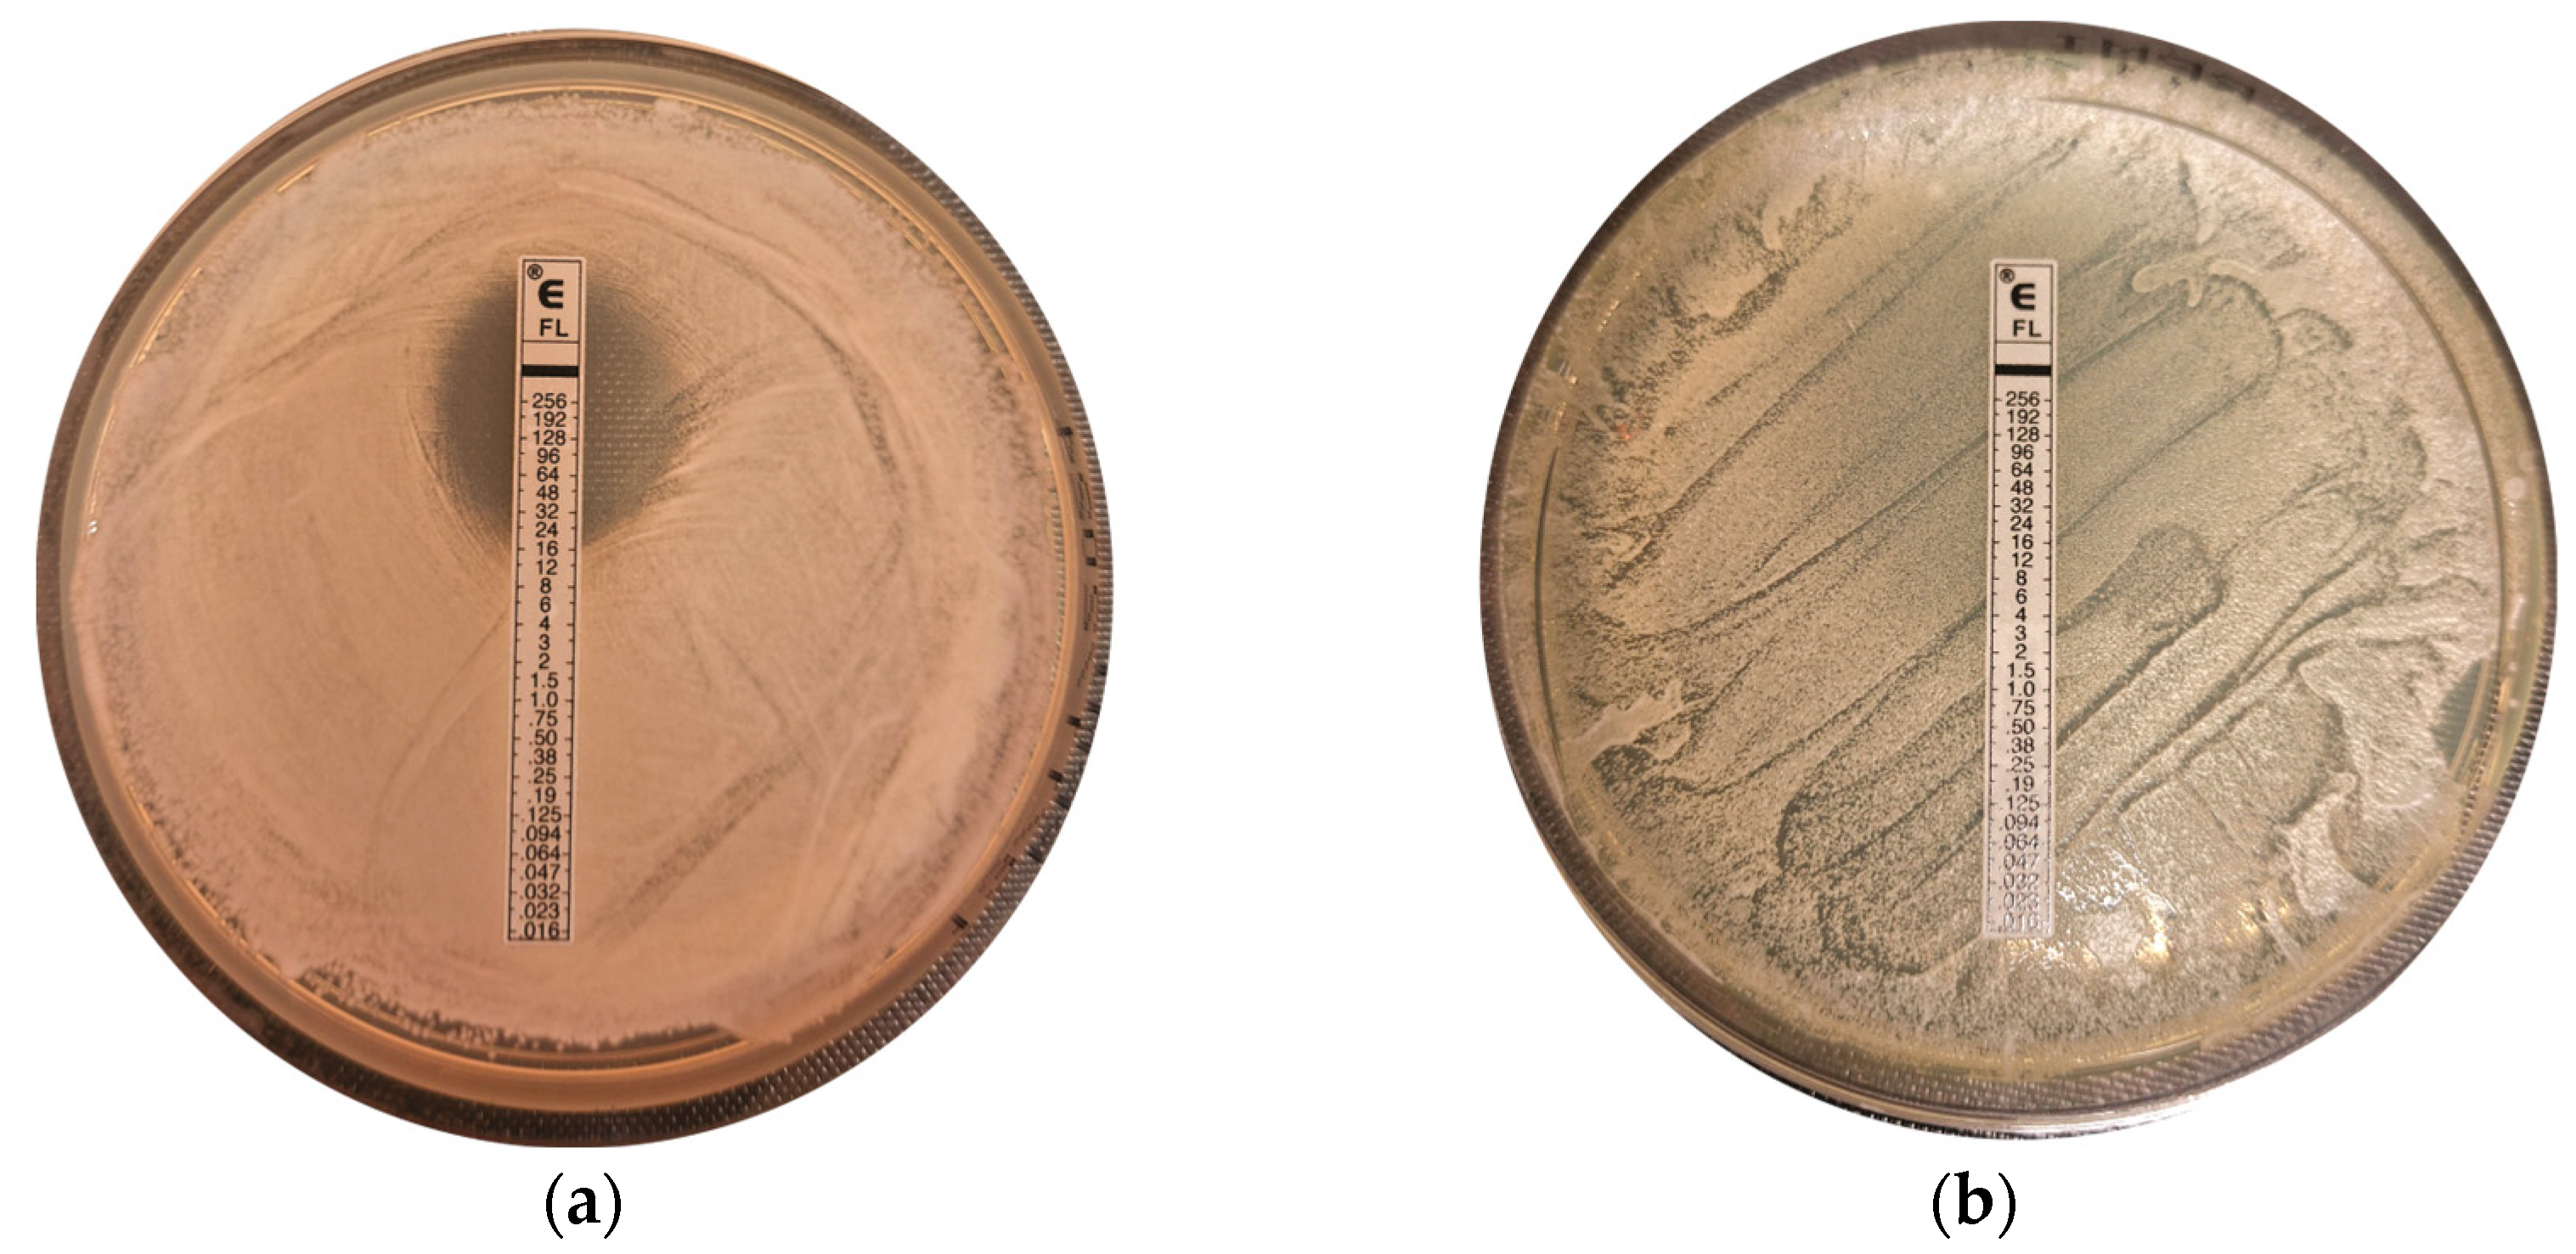
Applmicrobiol 05 00030 g002 Applmicrobiol 05 00030 g002

Harnessing Environmental Yeasts—Pichia kudriavzevii Strain ZMUM_K002: The Quest for Isolates with Properties for Efficient Biotechnological Applications
Abstract
1. Introduction
2. Materials and Methods
2.1. Collection of Samples and Selective Isolation of Yeasts
2.2. Yeast Identification Using ITS rDNA Region
2.3. Sporulation and Spore Stain
2.4. Fluconazole Susceptibility Testing
2.5. Evaluation of Growth on Different Carbon Sources
2.6. Evaluation of Growth in Chemically Defined Medium Supplemented with Selected Carbon Sources
2.7. Evaluation of Growth in YP Medium Supplemented with Glucose or Spent Coffee Grounds
2.8. Measurement of Optical Density (OD600)
2.9. Measurement of Wet Cell Weight
2.10. Statistical Analysis
3. Results
3.1. Sampling, Isolation, Purification, and Molecular Identification of the Yeast Strains
3.2. Morphological Characterization
3.3. Fluconazole Susceptibility
3.4. Utilization of Different Carbon Sources
3.5. Growth in Chemically Defined Medium Using Selected Carbon Sources
3.6. Growth in YP Medium Supplemented with Glucose or Spent Coffee Grounds
4. Discussion
5. Conclusions
Supplementary Materials
Author Contributions
Funding
Data Availability Statement
Acknowledgments
Conflicts of Interest
References
- Segal-Kischinevzky, C.; Romero-Aguilar, L.; Alcaraz, L.D.; López-Ortiz, G.; Martínez-Castillo, B.; Torres-Ramírez, N.; Sandoval, G.; González, J. Yeasts Inhabiting Extreme Environments and Their Biotechnological Applications. Microorganisms 2022, 10, 794. [Google Scholar] [CrossRef] [PubMed]
- Nandy, S.K.; Srivastava, R.K. A Review on Sustainable Yeast Biotechnological Processes and Applications. Microbiol. Res. 2018, 207, 83–90. [Google Scholar] [CrossRef]
- Martinić Cezar, T.; Marđetko, N.; Trontel, A.; Paić, A.; Slavica, A.; Teparić, R.; Žunar, B. Engineering Saccharomyces cerevisiae for the Production of Natural Osmolyte Glucosyl Glycerol from Sucrose and Glycerol through Ccw12-Based Surface Display of Sucrose Phosphorylase. J. Biol. Eng. 2024, 18, 69. [Google Scholar] [CrossRef] [PubMed]
- Procópio, D.P.; Lee, J.W.; Shin, J.; Tramontina, R.; Ávila, P.F.; Brenelli, L.B.; Squina, F.M.; Damasio, A.; Rabelo, S.C.; Goldbeck, R.; et al. Metabolic Engineering of Saccharomyces cerevisiae for Second-Generation Ethanol Production from Xylo-Oligosaccharides and Acetate. Sci. Rep. 2023, 13, 19182. [Google Scholar] [CrossRef]
- Lee, K.S.; Hong, M.E.; Jung, S.C.; Ha, S.J.; Yu, B.J.; Koo, H.M.; Park, S.M.; Seo, J.H.; Kweon, D.H.; Park, J.C.; et al. Improved Galactose Fermentation of Saccharomyces cerevisiae through Inverse Metabolic Engineering. Biotechnol. Bioeng. 2011, 108, 621–631. [Google Scholar] [CrossRef]
- Goddard, M.R.; Greig, D. Saccharomyces cerevisiae: A Nomadic Yeast with No Niche? FEMS Yeast Res. 2015, 15, fov009. [Google Scholar] [CrossRef]
- Ostergaard, S.; Olsson, L.; Nielsen, J. Metabolic Engineering of Saccharomyces cerevisiae. Microbiol. Mol. Biol. Rev. 2000, 64, 34–50. [Google Scholar] [CrossRef]
- Belda, I.; Ruiz, J.; Santos, A.; Van Wyk, N.; Pretorius, I.S. Saccharomyces Cerevisiae. Trends Genet. 2019, 35, 956–957. [Google Scholar] [CrossRef]
- Parapouli, M.; Vasileiadis, A.; Afendra, A.S.; Hatziloukas, E. Saccharomyces cerevisiae and Its Industrial Applications. AIMS Microbiol. 2020, 6, 1–31. [Google Scholar] [CrossRef]
- Hampsey, M. A Review of Phenotypes in Saccharomyces cerevisiae. Yeast 1997, 13, 1099–1133. [Google Scholar] [CrossRef]
- Schnierda, T.; Bauer, F.F.; Divol, B.; van Rensburg, E.; Görgens, J.F. Optimization of Carbon and Nitrogen Medium Components for Biomass Production Using Non-Saccharomyces Wine Yeasts. Lett. Appl. Microbiol. 2014, 58, 478–485. [Google Scholar] [CrossRef] [PubMed]
- Tiago, F.C.P.; Martins, F.S.; Rosa, C.A.; Nardi, R.M.D.; Cara, D.C.; Nicoli, J.R. Physiological Characterization of Non-Saccharomyces Yeasts from Agro-Industrial and Environmental Origins with Possible Probiotic Function. World J. Microbiol. Biotechnol. 2009, 25, 657–666. [Google Scholar] [CrossRef]
- Douglass, A.P.; Offei, B.; Braun-Galleani, S.; Coughlan, A.Y.; Martos, A.A.R.; Ortiz-Merino, R.A.; Byrne, K.P.; Wolfe, K.H. Population Genomics Shows No Distinction between Pathogenic Candida krusei and Environmental Pichia kudriavzevii: One Species, Four Names. PLoS Pathog. 2018, 14, e1007138. [Google Scholar] [CrossRef] [PubMed]
- Kurtzman, C.P.; Robnett, C.J.; Basehoar-Powers, E. Phylogenetic Relationships among Species of Pichia, Issatchenkia and Williopsis Determined from Multigene Sequence Analysis, and the Proposal of Barnettozyma Gen. Nov., Lindnera Gen. Nov. and Wickerhamomyces Gen. Nov. FEMS Yeast Res. 2008, 8, 939–954. [Google Scholar] [CrossRef]
- Chu, Y.; Li, M.; Jin, J.; Dong, X.; Xu, K.; Jin, L.; Qiao, Y.; Ji, H. Advances in the Application of the Non-Conventional Yeast Pichia kudriavzevii in Food and Biotechnology Industries. J. Fungi 2023, 9, 170. [Google Scholar] [CrossRef]
- Jiang, D.; Wang, M.; Zhao, X.; Lu, X.; Zong, H.; Zhuge, B. Glycerol Production from Undetoxified Lignocellulose Hydrolysate by a Multiresistant Engineered Candida glycerinogenes. J. Agric. Food Chem. 2024, 72, 1630–1639. [Google Scholar] [CrossRef]
- Xi, Y.; Zhan, T.; Xu, H.; Chen, J.; Bi, C.; Fan, F.; Zhang, X. Characterization of JEN Family Carboxylate Transporters from the Acid-Tolerant Yeast Pichia kudriavzevii and Their Applications in Succinic Acid Production. Microb. Biotechnol. 2021, 14, 1130–1147. [Google Scholar] [CrossRef]
- Pfaller, M.A.; Diekema, D.J.; Turnidge, J.D.; Castanheira, M.; Jones, R.N. Twenty Years of the SENTRY Antifungal Surveillance Program: Results for Candida Species from 1997–2016. Open Forum Infect. Dis. 2019, 6, S79–S94. [Google Scholar] [CrossRef]
- World Health Organization (WHO). WHO Fungal Priority Pathogens List to Guide Research, Development and Public. Health Action; WHO: Geneva, Switzerland, 2022. [Google Scholar]
- Nguyen, T.A.; Kim, H.Y.; Stocker, S.; Kidd, S.; Alastruey-Izquierdo, A.; Dao, A.; Harrison, T.; Wahyuningsih, R.; Rickerts, V.; Perfect, J.; et al. Pichia kudriavzevii (Candida krusei): A Systematic Review to Inform the World Health Organisation Priority List of Fungal Pathogens. Med. Mycol. 2024, 62, myad132. [Google Scholar] [CrossRef]
- Sokchea, H.; Thi Hang, P.; Dinh Phung, L.; Duc Ngoan, L.; Thu Hong, T.; Borin, K. Effect of Time, C/N Ratio and Molasses Concentration on Saccharomyces cerevisiae Biomass Production. J. Vet. Anim. Res. 2018, 1, 1–7. [Google Scholar] [CrossRef]
- Ferndahl, C.; Bonander, N.; Logez, C.; Wagner, R.; Gustafsson, L.; Larsson, C.; Hedfalk, K.; Darby, R.A.; Bill, R.M. Increasing Cell Biomass in Saccharomyces cerevisiae Increases Recombinant Protein Yield: The Use of a Respiratory Strain as a Microbial Cell Factory. Microb. Cell Fact. 2010, 9, 47. [Google Scholar] [CrossRef] [PubMed]
- Zhang, S.; Wang, J.; Jiang, H. Microbial Production of Value-Added Bioproducts and Enzymes from Molasses, a by-Product of Sugar Industry. Food Chem. 2021, 346, 128860. [Google Scholar] [CrossRef] [PubMed]
- Hawkins, G.M.; Doran-Peterson, J. A Strain of Saccharomyces cerevisiae Evolved for Fermentation of Lignocellulosic Biomass Displays Improved Growth and Fermentative Ability in High Solids Concentrations and in the Presence of Inhibitory Compounds. Biotechnol. Biofuels 2011, 4, 49. [Google Scholar] [CrossRef]
- Ballesteros, L.F.; Teixeira, J.A.; Mussatto, S.I. Chemical, Functional, and Structural Properties of Spent Coffee Grounds and Coffee Silverskin. Food Bioprocess. Technol. 2014, 7, 3493–3503. [Google Scholar] [CrossRef]
- Calheiros, D.; Dias, M.I.; Calhelha, R.C.; Barros, L.; Ferreira, I.C.F.R.; Fernandes, C.; Gonçalves, T. Antifungal Activity of Spent Coffee Ground Extracts. Microorganisms 2023, 11, 242. [Google Scholar] [CrossRef] [PubMed]
- Silva, C.S.; Gabriel, C.; Cerqueira, F.; Manso, M.C.; Vinha, A.F. Coffee Industrial Waste as a Natural Source of Bioactive Compounds with Antibacterial and Antifungal Activities. In The Battle Against Microbial Pathogens: Basic Science, Technological Advances and Educational Programs; FORMATEX: Guadalajara, Mexico, 2015; pp. 131–136. [Google Scholar]
- Makimura, K.; Mochizuki, T.; Hasegawa, A.; Uchida, K.; Saito, H.; Yamaguchi, H. Phylogenetic Classification of Trichophyton Mentagrophytes Complex Strains Based on DNA Sequences of Nuclear Ribosomal Internal Transcribed Spacer 1 Regions. J. Clin. Microbiol. 1998, 36, 2629–2633. [Google Scholar] [CrossRef]
- Johnson, M.; Zaretskaya, I.; Raytselis, Y.; Merezhuk, Y.; McGinnis, S.; Madden, T.L. NCBI BLAST: A Better Web Interface. Nucleic Acids Res. 2008, 36, W5–W9. [Google Scholar] [CrossRef]
- Neiman, A.M. Sporulation in the Budding Yeast Saccharomyces cerevisiae. Genetics 2011, 189, 737–765. [Google Scholar] [CrossRef]
- Arendrup, M.C.; Friberg, N.; Mares, M.; Kahlmeter, G.; Meletiadis, J.; Guinea, J.; Andersen, C.T.; Arikan-Akdagli, S.; Barchiesi, F.; Chryssanthou, E.; et al. How to Interpret MICs of Antifungal Compounds According to the Revised Clinical Breakpoints v. 10.0 European Committee on Antimicrobial Susceptibility Testing (EUCAST). Clin. Microbiol. Infect. 2020, 26, 1464–1472. [Google Scholar] [CrossRef]
- Rodriquez Tudela, J.L.; Donnelly, J.P.; Arendrup, M.C.; Arikan, S.; Barchiesi, F.; Bille, J.; Chryssanthou, E.; Cuenca-Estrella, M.; Dannaoui, E.; Denning, D.; et al. EUCAST Technical Note on Fluconazole: The European Committee on Antimicrobial Susceptibility Testing—Subcommittee on Antifungal Susceptibility Testing (EUCAST-AFST). Clin. Microbiol. Infect. 2008, 14, 193–195. [Google Scholar] [CrossRef][Green Version]
- Cuesta, I.; Bielza, C.; Cuenca-Estrella, M.; Larrañaga, P.; Rodríguez-Tudela, J.L. Evaluation by Data Mining Techniques of Fluconazole Breakpoints Established by the Clinical and Laboratory Standards Institute (CLSI) and Comparison with Those of the European Committee on Antimicrobial Susceptibility Testing (EUCAST). Antimicrob. Agents Chemother. 2010, 54, 1541–1546. [Google Scholar] [CrossRef] [PubMed]
- Cuesta, I.; Bielza, C.; Larrañaga, P.; Cuenca-Estrella, M.; de Laguna, F.B.; Rodríguez-Pardo, D.; Almirante, B.; Pahissa, A.; Rodríguez-Tudela, J.L. Data Mining Validation of Fluconazole Breakpoints Established by the European Committee on Antimicrobial Susceptibility Testing. Antimicrob. Agents Chemother. 2009, 53, 2949–2954. [Google Scholar] [CrossRef] [PubMed]
- Rogers, T.R.; Verweij, P.E.; Castanheira, M.; Dannaoui, E.; White, P.L.; Arendrup, M.C. Molecular Mechanisms of Acquired Antifungal Drug Resistance in Principal Fungal Pathogens and EUCAST Guidance for Their Laboratory Detection and Clinical Implications. J. Antimicrob. Chemother. 2022, 77, 2053–2073. [Google Scholar] [CrossRef] [PubMed]
- De Souza, P.C.; Morey, A.T.; Castanheira, G.M.; Bocate, K.P.; Panagio, L.A.; Ito, F.A.; Furlaneto, M.C.; Yamada-Ogatta, S.F.; Costa, I.N.; Mora-Montes, H.M.; et al. Tenebrio Molitor (Coleoptera: Tenebrionidae) as an Alternative Host to Study Fungal Infections. J. Microbiol. Methods 2015, 118, 182–186. [Google Scholar] [CrossRef]
- Wojda, I.; Staniec, B.; Sułek, M.; Kordaczuk, J. The Greater Wax Moth Galleria Mellonella: Biology and Use in Immune Studies. Pathog. Dis. 2020, 78, ftaa057. [Google Scholar] [CrossRef]
- Last, A.; Maurer, M.; Mosig, A.S.; Gresnigt, M.S.; Hube, B. In Vitro Infection Models to Study Fungal-Host Interactions. FEMS Microbiol. Rev. 2021, 45, fuab005. [Google Scholar] [CrossRef]
- Wang, Z.P.; Zhang, X.Y.; Ma, Y.; Ye, J.R.; Jiang, J.; Wang, H.Y.; Chen, W. Whole Conversion of Agro-Industrial Wastes Rich in Galactose-Based Carbohydrates into Lipid Using Oleaginous Yeast Aureobasidium namibiae. Biotechnol. Biofuels 2021, 14, 181. [Google Scholar] [CrossRef]
- Behera, S.; Arora, R.; Nandhagopal, N.; Kumar, S. Importance of Chemical Pretreatment for Bioconversion of Lignocellulosic Biomass. Renew. Sustain. Energy Rev. 2014, 36, 91–106. [Google Scholar] [CrossRef]
- Nweze, J.E.; Ndubuisi, I.; Murata, Y.; Omae, H.; Ogbonna, J.C. Isolation and Evaluation of Xylose-Fermenting Thermotolerant Yeasts for Bioethanol Production. Biofuels 2021, 12, 961–970. [Google Scholar] [CrossRef]
- Dobson, R.; Gray, V.; Rumbold, K. Microbial Utilization of Crude Glycerol for the Production of Value-Added Products. J. Ind. Microbiol. Biotechnol. 2012, 39, 217–226. [Google Scholar] [CrossRef]
- Díaz-Nava, L.E.; Montes-Garcia, N.; Domínguez, J.M.; Aguilar-Uscanga, M.G. Effect of Carbon Sources on the Growth and Ethanol Production of Native Yeast Pichia kudriavzevii ITV-S42 Isolated from Sweet Sorghum Juice. Bioprocess. Biosyst. Eng. 2017, 40, 1069–1077. [Google Scholar] [CrossRef] [PubMed]
- Elsayed, M.; Eraky, M.; Osman, A.I.; Wang, J.; Farghali, M.; Rashwan, A.K.; Yacoub, I.H.; Hanelt, D.; Abomohra, A. Sustainable Valorization of Waste Glycerol into Bioethanol and Biodiesel through Biocircular Approaches: A Review. Environ. Chem. Lett. 2024, 22, 609–634. [Google Scholar] [CrossRef]
- Gallardo, J.C.M.; Souza, C.S.; Cicarelli, R.M.B.; Oliveira, K.F.; Morais, M.R.; Laluce, C. Enrichment of a Continuous Culture of Saccharomyces cerevisiae with the Yeast Issatchenkia Orientalis in the Production of Ethanol at Increasing Temperatures. J. Ind. Microbiol. Biotechnol. 2011, 38, 405–414. [Google Scholar] [CrossRef]
- Merico, A.; Ragni, E.; Galafassi, S.; Popolo, L.; Compagno, C. Generation of an Evolved Saccharomyces cerevisiae Strain with a High Freeze Tolerance and an Improved Ability to Grow on Glycerol. J. Ind. Microbiol. Biotechnol. 2011, 38, 1037–1044. [Google Scholar] [CrossRef]
- Lages, F.; Lucas, C. Contribution to the Physiological Characterization of Glycerol Active Uptake in Saccharomyces cerevisiae. Biochim. Biophys. Acta (BBA)-Bioenerg. 1997, 1322, 8–18. [Google Scholar] [CrossRef]
- Oliveira, R.; Lucas, C. Expression Studies of GUP1 and GUP2, Genes Involved in Glycerol Active Transport in Saccharomyces cerevisiae, Using Semi-Quantitative RT-PCR. Curr. Genet. 2004, 46, 140–146. [Google Scholar] [CrossRef]
- Zhang, J.; Reddy, J.; Buckland, B.; Greasham, R. Toward Consistent and Productive Complex Media for Industrial Fermentations: Studies on Yeast Extract for a Recombinant Yeast Fermentation Process. Biotechnol. Bioeng. 2003, 82, 640–652. [Google Scholar] [CrossRef]
- Abelovska, L.; Bujdos, M.; Kubova, J.; Petrezselyova, S.; Nosek, J.; Tomaska, L. Comparison of Element Levels in Minimal and Complex Yeast Media. Can. J. Microbiol. 2007, 53, 533–535. [Google Scholar] [CrossRef]

| Yeast Strain | Pichia kudriavzevii ZMUM_K002 | Saccharomyces cerevisiae ZMUM_K003 | |||
|---|---|---|---|---|---|
| Carbon Source | Utilization | Gas | Utilization | Gas | |
| Monosaccharides | |||||
| glucose | + | + | + | + | |
| fructose | + | + | + | + | |
| galactose | − | − | + | + | |
| D-mannose | + | − | + | − | |
| xylose | − | − | − | − | |
| Disaccharides | |||||
| sucrose | +/− * | − | + | − | |
| lactose | − | − | +/− * | − | |
| maltose | − | − | + | − | |
| Polysaccharides | |||||
| starch | − | − | + | + | |
| methyl cellulose | − | − | − | − | |
| Polyols | |||||
| glycerol | +/− * | − | +/− * | − | |
| D-sorbitol | − | − | − | − | |
| D-mannitol | − | − | − | − | |
Disclaimer/Publisher’s Note: The statements, opinions and data contained in all publications are solely those of the individual author(s) and contributor(s) and not of MDPI and/or the editor(s). MDPI and/or the editor(s) disclaim responsibility for any injury to people or property resulting from any ideas, methods, instructions or products referred to in the content. |
© 2025 by the authors. Licensee MDPI, Basel, Switzerland. This article is an open access article distributed under the terms and conditions of the Creative Commons Attribution (CC BY) license (https://creativecommons.org/licenses/by/4.0/).
Share and Cite
Vajdič, T.; Erjavec, M.S. Harnessing Environmental Yeasts—Pichia kudriavzevii Strain ZMUM_K002: The Quest for Isolates with Properties for Efficient Biotechnological Applications. Appl. Microbiol. 2025, 5, 30. https://doi.org/10.3390/applmicrobiol5010030
Vajdič T, Erjavec MS. Harnessing Environmental Yeasts—Pichia kudriavzevii Strain ZMUM_K002: The Quest for Isolates with Properties for Efficient Biotechnological Applications. Applied Microbiology. 2025; 5(1):30. https://doi.org/10.3390/applmicrobiol5010030
Chicago/Turabian StyleVajdič, Tadeja, and Marjanca Starčič Erjavec. 2025. "Harnessing Environmental Yeasts—Pichia kudriavzevii Strain ZMUM_K002: The Quest for Isolates with Properties for Efficient Biotechnological Applications" Applied Microbiology 5, no. 1: 30. https://doi.org/10.3390/applmicrobiol5010030
APA StyleVajdič, T., & Erjavec, M. S. (2025). Harnessing Environmental Yeasts—Pichia kudriavzevii Strain ZMUM_K002: The Quest for Isolates with Properties for Efficient Biotechnological Applications. Applied Microbiology, 5(1), 30. https://doi.org/10.3390/applmicrobiol5010030

